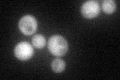
YOL052C
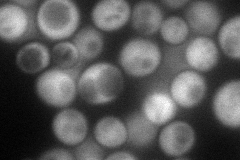
YOL052C
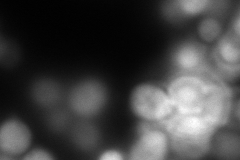
YOL052C
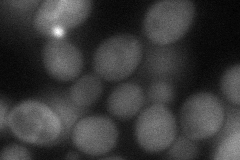
YOL052C
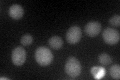
YOL052C

View description
S-adenosylmethionine decarboxylase, required for the biosynthesis of spermidine and spermine; cells lacking Spe2p require spermine or spermidine for growth in the presence of oxygen but not when grown anaerobically
Localization:
Intensity:
Fold change:
Significance:
-
C’ GFP library in SD
cytosol51.17 -
N' NOP1pr-GFP in SD
cytosol103.968 -
N' TEF2pr-mCherry in SD
cytosol0 -
N' NATIVEpr-GFP in SD

cytosol29.2271 -
N' TEF2pr-VC and Cyto-VN in SD
cytosol61.3386 -
C’ GFP library in SD+DTT

cytosol49.480.96No -
C’ GFP library in SD+H2O2

cytosol58.051.13No -
C’ GFP library in Starvation Media
cytosol71.611.39Yes -
C’ GFP library on the background of Pup2-DaMP

cytosol -
C’ GFP library on the background of CCT mutant

cytosol49.79940.973056No
